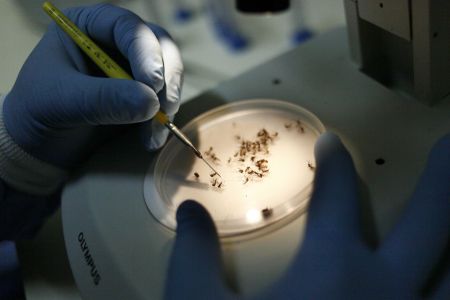
Rio de Janeiro confirma dois casos de dengue tipo 3; sorotipo não era registrado desde 2007 | CNN Brasil

Dengue pode elevar em 17 vezes risco de síndrome de Guillain-Barré
Síndrome pode causar paralisia total e deixar sequelas permanentes
Um estudo da Fundação Oswaldo Cruz (Fiocruz) revelou que pessoas infectadas pelo vírus da dengue têm 17 vezes mais chance de desenvolver a síndrome de Guillain-Barré (SGB) nas seis semanas seguintes à infecção. Nas duas primeiras semanas após o início dos sintomas da doença, o risco é 30 vezes maior.
A pesquisa foi publicada na revista científica New England Journal of Medicine nessa quarta-feira (15). A literatura científica contava com relatos isolados de pacientes que desenvolveram SGB após uma infecção por dengue, mas nenhum estudo havia quantificado esse risco de forma significativa.
Os autores do estudo chegaram à conclusão usando dados do Sistema Único de Saúde (SUS). Eles consideraram internações hospitalares, notificações de casos de dengue e registros de óbitos. Foram identificadas mais de 5 mil hospitalizações por SGB entre 2023 e 2024. Dessas, 89 ocorreram logo após o paciente apresentar dengue.
O que é Síndrome de Guillain-Barré
A síndrome de Guillain-Barré é uma condição neurológica rara em que o sistema imunológico ataca os nervos periféricos, prejudicando as células que conectam o cérebro e a medula espinhal ao resto do corpo.
Os pacientes com SGB apresentam fraqueza muscular, geralmente iniciada nas pernas, que pode subir para os braços, rosto e, em casos graves,pode dificultar a respiração. A pessoa pode ficar completamente paralisada e necessitar da ajuda de aparelhos para respirar.
A maioria dos pacientes se recupera. Porém, o processo pode levar anos, e algumas pessoas ficam com sequelas permanentes.
Formada em Jornalismo pela Puc Minas, Paula Arantes produziu inicialmente conteúdos para as editorias Minas Gerais, Brasil, Mundo, Orações e Entretenimento no portal da Itatiaia. Atualmente, colabora com a editoria Meio Ambiente. Antes, passou pelo jornal Estado de Minas.
